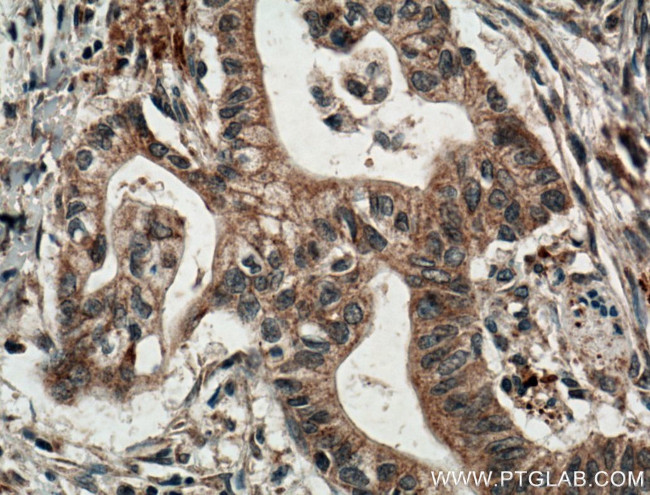
IRE1/ERN1 Antibody in Immunohistochemistry (Paraffin) (IHC (P))
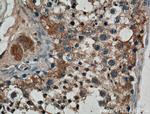
IRE1/ERN1 Antibody in Immunohistochemistry (Paraffin) (IHC (P))

Search
Proteintech
IRE1/ERN1 Polyclonal Antibody
{{$productOrderCtrl.translations['antibody.pdp.commerceCard.promotion.promotions']}}
{{$productOrderCtrl.translations['antibody.pdp.commerceCard.promotion.viewpromo']}}
{{$productOrderCtrl.translations['antibody.pdp.commerceCard.promotion.promocode']}}: {{promo.promoCode}} {{promo.promoTitle}} {{promo.promoDescription}}. {{$productOrderCtrl.translations['antibody.pdp.commerceCard.promotion.learnmore']}}
产品信息
27528-1-AP
种属反应
宿主/亚型
分类
类型
抗原
偶联物
形式
浓度
规格
纯化类型
保存液
内含物
保存条件
运输条件
产品详细信息
Immunogen sequence: PLSASTKML ERFPNNLPKH RENVIPADSE KKSFEEVINL VDQTSENAPT TVSRDVEEKP AHAPARPEAP VDSMLKDMAT IILSTFLLIG WVAFIITYPL SMHQQQQLQH QQFQKELEKI QLLQQQQQQL PFHPPGDTAQ DGELLDTSGP YSESSGTSSP STSPRASNHS LCSGSSASKA GSSPSLEQDD GDEETSVVI (368-565 aa encoded by BC130405)
靶标信息
ERN1 serine/threonine kinase or endoplasmic reticulum to nucleus signaling 1 is the ER to nucleus signaling 1 protein, a human homologue of the yeast Ire1 gene product which possesses intrinsic kinase activity and an endoribonuclease activity and it is important in endoplasmic reticulum-based stress signals. ERN1 controls IRE1 proteolysis in mammalian cells. ERN1 has a critical function in extraembryonic cells that is essential for fetal viability. Specifically, IRE1 acts as the sensor of unfolded proteins in the ER that initiates transmittance of the unfolded protein signal from the ER to the nucleus by splicing XBP1 mRNA converting it into a potent unfolded-protein response transcriptional activator. Null mutants are viable, but IRE1 is essential for viability under stress conditions that cause unfolded proteins to accumulate in the ER. Depletion of IRE1p through the expression of a dominant negative form of IRE1p has no effect on transfected cells, but cell death via apoptosis occurs under stress conditions that cause unfolded proteins to accumulate in the ER.
仅用于科研。不用于诊断过程。未经明确授权不得转售。
生物信息学
蛋白别名: Endoplasmic reticulum-to-nucleus signaling 1; ER to nucleus signalling 1; FLJ30999; hIRE1p; inositol-requiring 1; inositol-requiring enzyme 1; Inositol-requiring protein 1; Ire1-alpha; IRE1a; IRE1a antibody; Ire1p; IRE1p antibody; MGC163277; MGC163279; protein kinase/endoribonuclease; Serine/threonine-protein kinase/endoribonuclease IRE1; unnamed protein product
基因别名: ERN1; hIRE1p; IRE1; IRE1a; IRE1P
UniProt ID: (Human) O75460
Entrez Gene ID: (Human) 2081